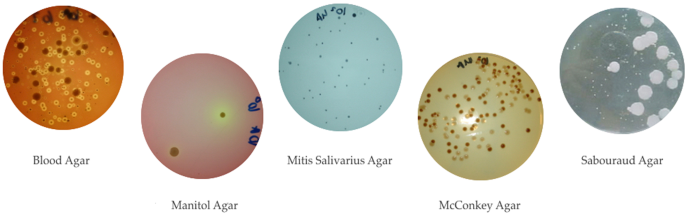
Figure 1

Abstract
Three different bioadhesive gels were evaluated in a double-blind randomized clinical trial in which microbial growth in the suture thread was assessed following post-surgical application of the aforementioned gels. Also assessed in this trial were, the intensity of post-surgical pain as well as the degree of healing of the patients’ surgical wounds. A total of 21 patients (with 42 wisdom teeth) participated in this trial. Chlorhexidine gel, chlorhexidine-chitosan gel, and hyaluronic acid gel were evaluated, with a neutral water-based gel serving as the control agent. The aerobic and facultative anaerobic bacterial recovery on blood agar was lower in the placebo group than in the experimental groups. The most significant difference (p = 0.04) was observed in the chlorhexidine-chitosan group. in which the growth of Blood Agar and Mitis Salivarius Agar was significantly higher than in the placebo group. The intensity of post-surgical pain was very similar among all the groups. Significantly better healing rates were observed in the patients treated with chlorhexidine-chitosan gel when compared with those who used the placebo gel (p = 0.03), and in particular when compared with those patients who used hyaluronic acid gel (p = 0.01). Through our microbiological analyses, we were able to conclude that none of the bioadhesive gels tested resulted in beneficial reductions in the bacterial/fungal populations. However, the healing rates of patients who were treated with chlorhexidine-chitosan were better than those of the patients who used either the placebo gel or the hyaluronic acid gel.
Similar content being viewed by others
Introduction
The lower third molars are the most commonly impacted teeth, with a calculated impaction incidence of 33% of the population1,2,3. Complications arising from impaction are very frequent, and in fact, pericoronitis accounts for approximately 50% of indicated tooth extractions. The remaining 50% of all extractions are indicated due to cavities in the second molar; for orthodontic reasons; or because of the presence of cysts or non-infection-related pain4,5. As such, the surgical removal of the third molars is one of the most frequently conducted oral surgery procedures.
The initial phase in the healing of a wound usually consists of wound closure through suturation. The most commonly used suture threads in third molar surgical procedures are 3–0 or 4–0 braided natural suture silk6. These particular threads are favoured because of their capacity to retain tensile strength7,8; their acceptable tissue reaction9; and also due to the fact that they are excellent value for the money.
The fact that the sutures used in impacted third molar extractions are susceptible to the adhesion of pathogenic bacteria10 is considered a risk factor11 for the healing of surgical wounds. Microbial adhesion and accumulation on the sutures inside the mouth may act as a focus of odontogenic infection12. Said infections can be caused by both aerobic and anaerobic bacteria, including species of the Fusobacterium, Peptostreptococcus, Prevotella, Porphyromonas, Streptococcus, and Bacteroides genera, or yeasts such as Candida albicans13.
The use of oral antiseptics before and after the surgical procedure is an efficient way of reducing the microbiota and of preventing post-surgical complications14,15. In addition, oral antiseptics help to prevent bacteria spreading through the blood16, thus decreasing the risk of bacterial endocarditis17,18.
It is now widely accepted that, out of all of the antimicrobial agents which are used to reduce the number of microorganisms in the mouth, chlorhexidine digluconate is the safest and most efficient option19,20,21. However, there are a number of known adverse effects of chlorhexidine digluconate. These include the formation of stains on teeth and dental prostheses22,23; dysgeusia and ageusia24,25; parotid enlargement (which depends on the exposure period)26; and the desquamation of the epithelium of the oral mucosa27. Chlorhexidine is primarily used in mouthwashes and, given that it comes into contact with all areas of the mouth, it has been associated with the aforementioned complications28,29.
Chlorhexidine can also be used in different kinds of gels. Recent studies have shown that the application of chlorhexidine gel following the surgical management of impacted third molars can significantly reduce infectious complications30.
In recent years, laboratories have taken steps to improve the substantivity of chlorhexidine; developing formulations for increased adhesion to the mouth’s surface, and these have been attained through the use of agents with bioadhesive properties31.
Decker et al.32 observed an important synergistic effect when combining chlorhexidine and chitosan, as this resulted in bacterial reduction. Chitosan is a polysaccharide derived from chitin which can be found in the arthropod cuticle; in marine fauna such as the squid; and in the cell wall of fungi34. This biomolecule displays interesting bioadhesive properties on oral tissue33.
Chitosan boasts antibacterial35,36,37 and antifungal38 properties, and is known for its high degree of biocompatibility38,39,40. Moreover, it has previously been described in the scientific literature as a wound-healing agent39,40,41,42,43; a drug delivery system for the slow release of different topical44,45,46,47 and systemic drugs46,48; a hemostatic agent49,50; and biomaterial for bone51 and cartilage52,53 regeneration. In addition, the use of chitosan membranes for guided bone regeneration has been considered54.
Due to its excellent bioadhesive properties and its high adherence to oral surfaces, chitosan is considered as the perfect vehicle for permitting increased substantivity, and likewise it is used to prolong the release of different oral therapeutic agents55 such as chlorhexidine.
It has also been demonstrated that hyaluronic acid gel offers a similar healing-inducing effect and antimicrobial activity. Hyaluronic acid is a glycosaminoglycan which is found in connective tissue, and which boasts a wide range of healing properties during the tissue creation and repair processes, including cell migration and differentiation56. Recent studies have indicated that it also plays an important role in the healing process of both soft and hard tissues57,58. In addition to its well-documented regenerative properties59, its bacteriostatic effect on numerous oral bacteria such as Streptococcus mutans, Porphyromonas gingivalis, Prevotella oris, Actinobacillus actinomycentencomitans, Staphylococcus aureus and other bacteria that are usually found in the oral flora60,61 has also been demonstrated. This effect depends on the molecular weight of hyaluronic acid and its concentration in the product. Hyaluronic acid is also effective against colonization by Candida albicans62. It also has analgesic properties63 and is known to protect the treated area from contaminants. It does so by creating a barrier to protect the wound from macromolecules and other substances that could be used by bacteria as a substrate64.
The aim of this study was to evaluate the use of different bioadhesive gels by assessing the growth of bacteria and fungi present on the suturing thread; the intensity of post-surgical pain; and the degree of healing of surgical wounds following the application of these different post-surgical bioadhesive gels.
Material and Methods
Type of study
In order to attain the study objective, a double-blind randomized clinical trial was performed. The study protocol was approved by the Clinical Research Ethics Committee of Galicia, and was assigned the reference code 2014/337. This project did not receive funding from any private entity. The authors declare that there are no conflicts of interest. The clinical trial was registered on ClinicalTrials.gov (ID: NCT03188289) on the 15 June 2017.
Study population
A total of 21 patients from the Faculty of Medicine and Odontology of the University of Santiago de Compostela participated in the study from 15 January 2014 to 15 July 2014. The participating patients visited the Clinic of Oral Medicine, Oral Surgery, and Implantology for the surgical extraction of, at minimum, both of their inferior wisdom teeth.
Inclusion and exclusion criteria
After the clinical history of each patient who attended the clinic for the surgical removal of the lower third molars was obtained, participants underwent an oral examination before their compliance with the following inclusion criteria was thoroughly evaluated; age (between 18 and 39 years); good general health; availability during the study period; no current or pending treatments during the study period; the patient’s acceptance and compliance with the prescribed oral hygiene instructions; and his or her commitment not to use any antiseptic mouthwash or toothpaste during the study period. The exclusion criteria were as follows: use of antimicrobial mouthwash or toothpaste during the period in which the sutures remain in the patient’s mouth; a diagnosis of diabetes; a diagnosis of a degenerative disease; the patient is a smoker; deficient oral health (cavities, periodontal disease, pathologies of the oral mucosa, etc.); use of prosthetic or orthodontic devices; an amoxicillin allergy; pregnancy or lactation.
Patients who did not meet these criteria were excluded from the study, but did continue to receive the surgical treatment that had previously been planned for them in the Clinic of Oral Medicine, Oral Surgery, and Implantology. Patients who met the inclusion criteria were able to voluntarily choose to participate in the study, or to refrain from doing so.
Randomization
All of the patients who agreed to participate in the study and who signed informed consent forms were randomly assigned to one of three groups. The principal researcher generated a randomization sequence in which the participants were selected and assigned to the different treatment groups.
In order to do this, a table containing three columns (A, B, and C) was created. The name of each patient was written on a small piece of paper which was then placed in a completely opaque bag. The contents of the bag were shuffled before the names were randomly drawn. Each name drawn was assigned to one of groups, alternating among the three groups, which were assigned the letters A, B, and C. In this manner three groups, each containing seven participants, were formed. The names of the three gels which were to be used in this study were then placed in the same bag. The name of the first gel that was drawn was assigned to group A; the second to group B; and the third to group C.
Study protocol
Surgical planning
All of the patients who agreed to participate in the study and who signed the informed consent forms and the specific form for oral surgery were then each given an individual appointment.
The appointments for study participants were scheduled for different dates and times in the Clinic of Oral Medicine, Oral Surgery, and Implantology of the Faculty of Odontology of the University of Santiago de Compostela exactly as would have been done if they had not agreed to participate in the study.
The choice of which of the two inferior wisdom teeth to remove first (i.e., the right or the left) was made by flipping a coin. Prior to each surgical intervention, the clinical and radiographic parameters were examined in order to assess the perceived difficulty of the tooth extraction. The analyzed parameters were the degree of eruption; the facial landmarks65,66(i.e., the distance from the tragus to the corner of the mouth, between the mandible and the external corner of the eye, between the corner of the lip and the mandible, the inter-incisal distance; and both the Pell and Gregory67, and Winter68 radiographic classifications.
Upon completion of the surgery, the wound was sutured using 4–0 braided natural silk and the patient was given instructions regarding their post-surgical care.
Post-surgical care and gels under study
The participants were prescribed 750 mg of Amoxicillin every eight hours for seven days, and 600 mg of ibuprofen every eight hours for three days. If the patients continued to experience pain after the initial three-day prescription, the same dose of ibuprofen could be administered as needed. Each patient was also provided with a coded sterile container containing 20 ml of one of the bioadhesive gels under study:
-
Chlorhexidine 0.2% gel (Bexident Gel Gingival ®)
-
Chlorhexidine 0.2% gel + Chitosan (Bexident Post ®)
-
Hyaluronic acid gel (ODDENT ®)
The patients were informed that this was the only antiseptic and healing-inducing gel that they were permitted to use during the seven-day period before the sutures in their mouths were removed.
The antiseptic gels were allocated randomly in the “double-blind” manner described above. Thus, neither the person performing the microbiological analysis nor the patient was aware of which treatment gel was being used in each instance.
The patients were instructed to apply the gel to the wound area and to the suture thread using a cotton swab, three times a day after brushing their teeth.
First control visit and suture removal
Seven days after the surgical procedure had been performed on each of the patients, he or she visited the Clinic in order for the suture threads to be removed and for the general condition of the surgical wound to be assessed. Facial swelling and trismus measurements as well as intraoral pictures were taken in order to determine the extent of healing. In addition, patients were asked to use a visual analog pain scale to evaluate their overall pain level during the seven-day period following the surgical procedure. Approximately one cm of the surgical thread that was in contact with the patient’s mouth was collected and then preserved in a PBS (phosphate-buffered saline) medium (Gibco, Waltham, USA) for bacterial preservation. This sample was subsequently sent to the Faculty of Medicine’s microbiology laboratory, where the microbiological analysis described below was performed.
Creation of the control group
In order to create the control group, the third contralateral molar was extracted from these patients’ mouths in the exact same manner as in the study group. The only difference was in the bioadhesive gel that was used after the surgical procedure was performed.
Thus, for the control group, a neutral water-based gel without any active ingredients was used. This will subsequently be referred to as the “placebo gel”. Its brand name is HISPAGEL 200 ® (Acofarma, Madrid, Spain).
Organizational chart and evaluation of clinical parameters
In each experiment, the patient visited the clinic on two separate occasions (day zero: day of surgery, and day seven: suture removal). This protocol was followed for both experiments.
In total, each patient visited the clinic on five different occasions. During their first visit, their clinical history was taken, the procedure was explained, and they were offered the possibility of participating in the study. If the patient gave their consent for their participation in the study, four more visits were scheduled in order for each lower wisdom tooth to be extracted and for the surgical sutures to subsequently be removed.
The same examiner collected all the samples, took the intraoral pictures of the wound after the sutures had been removed, and gathered the data recorded from the visual analog pain scale as indicated by the patient.
The clinical parameters were also analyzed, and their association to the microbiological parameters was verified.
For the subjective evaluation of post-surgical pain, a visual analog pain scale ranging from 0 to 10 was used, where 0 represented “no pain” and 10 “the worst pain imaginable”.
In order to assess the quality of healing, and given the lack of existence of a validated scale in the scientific literature on the healing of oral mucosa, it was decided to follow the work of Bloemen et. al.69 on wound healing, in which it is demonstrated that there are no significant differences between subjective assessment and assessments by means of computer software. Therefore four levels of healing were established: 1. Erythema present in operated area with signs of inflammation and infection. 2. Erythema present in operated area without any signs of infection. 3. Normal colouring in operated area and initial epithelialization. 4. Normal colouring in operated area and advanced epithelialization.
Microbiological analysis
The samples were analyzed in the Microbiology Laboratory of the Parasitology Department of the Faculty of Medicine of the University of Santiago de Compostela. The collected samples of suture thread were immersed in phosphate-buffered saline solution (PBS) immediately after their removal and these were kept refrigerated until their microbiological analysis. The samples were shaken vigorously for two minutes in order to separate the bacteria from the suture thread, and in order to obtain a homogeneous suspension. 10-fold serial dilutions in saline were subsequently prepared (10–1 to 10–5). Aliquots (50 microliters) of each dilution were plated in Petri dishes containing the different culture media (Fig. 1): Assays were performed in duplicate. The culture media used were: 1.) Columbia Blood agar (Liofilchem®, Italy) for the growth of aerobic and facultative anaerobic microorganisms; 2.) Mitis salivarius agar with 0.2 IU/ml of bacitracin and 15% sucrose (MSB) (Liofilchem®, Italy) for the growth of Streptococcus mutans: 3.) Mannitol agar (Liofilchem®, Italy) for the growth of Staphylococcus spp.; 4.) MacConkey agar (Liofilchem®, Italy) for the growth of Enterobacteriaceae and Pseudomonas spp.; 5.) Sabouraud dextrose agar (Liofilchem®, Italy) containing 0.1 mg/ml of chloramphenicol for the growth of Candida spp.
Photograph of the bacterial growth in the different culture media. (Attached file).
The blood agar, mannitol agar, MacConkey agar, and Sabouraud agar plates were aerobically incubated at 37 °C for 24–48 hours. The MSB agar plates were incubated in 5% CO2 at 37 °C for 48–72 hours.
After incubation, the colony forming units (CFUs) were counted and the total number of CFUs per milliliter of initial solution was calculated.
Safety assessment
Patient discomfort and the other risks inherent to this study were considered to be equivalent to those of normal clinical practice. Therefore, taking out a specific insurance policy for this purpose was not considered necessary.
Statistical analysis
In order to calculate the sample size, the average number of patients visiting the clinic annually for surgical extractions which included the third molar was used. With an average of 1000 patients per year, with 15% of these patients presenting with third molar pathology, and with a standard deviation of five, the inclusion of 42 third molars in this study results in a statistical power of 98%. These calculations were performed using Epidat 4.2 (SERGAS Galician Healthcare Service, Galicia, Spain). The data were analyzed using the SPSS (IBM SPSS Statistics 22 for MAC OX) predictive analysis software. The microbiological results and the clinical analyses were initially subjected to the Kolmogorov-Smirnov goodness-of-fit and the Shapiro-Wilk normality distribution test. If the data distribution resulted normal, the Student’s t-test was then used to perform a pairwise comparison. In the case of non-normal distribution, the Mann-Whitney U test was applied. The results were considered to be statistically significant when p ≤ 0.05.
Ethical approval
All procedures performed in studies involving human participants were in accordance with the ethical standards of the Clinical Research Ethics Committee of Galicia recorded under code 2014/337, and with the 1964 Helsinki declaration and its subsequent amendments or comparable ethical standards.
Informed consent
Informed consent was obtained from all individual participants involved in the study.
Results
Position of the wisdom teeth
A total of 21 patients participated in this study: 5 men (23.8%) and 16 women (76.2%). The average age of the patients in this study was 24.5 years, with a standard deviation of 4.1 years and an age range from 18 to 37 years. With regards to the degree of eruption, 52.4% of the wisdom teeth were unerupted, followed by 33.33% that were partially erupted, and only 14.3% of the extracted wisdom teeth had completely erupted at the time of surgery. The spatial orientation of the wisdom teeth was assessed using Winter’s classification. According to this classification, the vertical position was predominant, accounting for 50% of the 42 analyzed wisdom teeth, while 45.2% of wisdom teeth were in a mesioangular position, and less than 5% were in a distoangular position. In this study, no wisdom teeth were found in horizontal, transversal or inverted positions. According to the Pell and Gregory classification, all of the positions, (except for positions 2 C and 3 C) appeared in different proportions. Position 2 A was predominant, and this was present in more than 1 in 4 patients, (26.2%), and the incidence of positions, 1 A and 2B each appeared in 19.1% of patients respectively. Positions 2 C and 1 C accounted for 11.9% and 7.1%, respectively, while position 3 A appeared in only one of the studied cases, representing just 2.3% of the total sample. The frequency of these variables is shown in Table 1.
It was determined that the classification of the degree of inclusion by means of the Pell and Gregory scale or Winter’s scale was consistent with the study’s clinical and microbiological results.
Analysis of microbiological growth
No significant differences were detected in the mannitol, Sabouraud, and MacConkey agar media CFU counts between the placebo and any of the three experimental gels. Nevertheless the Streptococcus mutans counts from gels containing chlorhexidine (alone, or in combination with chitosan) were higher than those recorded with the placebo gel. The samples from the participants who used the chlorhexidine-chitosan gels showed not only higher S. mutans counts (p = 0.004) but also significant differences in the blood agar counts compared with the placebo levels (p = 0.047). Conversely, there was no difference in the blood agar counts when using the gels containing only chlorhexidine, compared to the placebo.
In terms of bacterial recoveries from hyaluronic gel samples, there was no significant difference with either the placebo or with gels containing chlorhexidine, regardless of the medium used for recovery.
Significant differences in the bacterial recoveries in the cases of partially erupted and completely impacted wisdom teeth were observed. The CFU counts were significantly higher in partially erupted teeth in both blood agar (aerobic and anaerobic CFUs) (p = 0.030) and MSB (Streptococcus mutans CFUs) (p = 0.001). The CFU counts in both blood agar (p = 0.043) and MSB (0.014) cultures were significantly higher in mesioangular wisdom teeth than in distoangular wisdom teeth. Conversely, Streptococcus mutans CFU counts were significantly higher in mesioangular wisdom teeth than in vertical wisdom teeth (p = 0.014).
Table 2 shows bacterial growth in the different culture media depending on the gels used in the postoperative period.
Analysis of post-surgical pain
Post-surgical pain was closely correlated with the quantity of analgesics consumed by the patients. All the patients included in the study received the mandatory prescription for 3 days, and none needed any extra dosage, hence the pain level score measures by VAS was not affected by the medication. Statistical analysis indicated that, regardless of the gel applied, the level of post-surgical pain described by the patients (using the visual analog pain scale) was very similar, and no significant differences were recorded. The mean pain level was 4.18 out of 10. The lowest pain level, 3.29 out of 10, was reported following the application of chlorhexidine gel; however, this difference was not considered statistically significant.
In total, 82.6% of the patients with low pain levels showed a “good” or “very good” degree of healing. There was no significant statistical relationship between the degree of pain and the type of gel used.
The distribution of the patients’ pain thresholds, both in the study and the control group, as well as their statistical significance, are shown in Tables 3 and 4.
Analysis of the degree of healing
The results from the Mann-Whitney U test for the two independent samples have been included in Table 4. The degree of healing of participants in the chlorhexidine-chitosan gel group was significantly greater than that of the participants in the placebo gel group (U = 34.500; p = 0.03). Similarly, the patients belonging to the chlorhexidine-chitosan gel group showed healing levels that were superior to those of the patients in the hyaluronic acid gel group, with an even greater difference than when compared to the placebo gel group (U = 6.000; p = 0.01).
No statistical differences were observed in the other comparisons with regard to the degree of healing.
The distribution of the degree of healing according to the bioadhesive gel used is indicated in Table 5.
Analysis of facial swelling and trismus
Statistical analysis indicated that, regardless of the gel applied, the post-surgical swelling and the trismus measurements between the anatomical landmarks before the surgical procedure was performed, and then seven days afterward, were not statistically different.
The average values before and after surgery are reflected in Table 6.
Discussion
In this clinical study, the antimicrobial effect of three bioadhesive gels used following the extraction of the lower third molars were assessed. Data on post-surgical pain, swelling, and the quality of healing were also evaluated.
This study confirmed the findings of Falci et al.70 regarding the prevalence of the positions of the wisdom teeth, indicating that the most common positions were vertical in Winter’s scale (50%), and position 2 in the Pell and Gregory classification (26%).
The microbiological analysis of the samples indicated that there were some significant differences in the microbiological growth on the suture thread among the different gels. The most noteworthy difference was observed in the levels of growth of CFUs (blood agar) between the chlorhexidine-chitosan and the placebo gel, with bacteria growth being significantly higher in the chlorhexidine-chitosan group. The authors believe that this could be related to the possibility that some bacteria use chitosan in their metabolism through chitosanases71.
The Streptococcus mutans recovery (Mitis salivarius agar) was lower in the placebo group than in the chlorhexidine gel and chlorhexidine-chitosan gel groups. This effect was paradoxical, given that there are studies which demonstrate that chlorhexidine, both in mouthwashes and in gels, is the substance that has the greatest effect on the Streptococcus mutans on dental plaque. A study by Emilson et al.72 indicated that chlorhexidine is considered the gold standard for combatting Streptococcus mutans. Other authors also confirmed the capacity of chitosan, in varying forms, for reducing the load of this bacterium73,74. However, all such studies consider the effect of the mouthwash outside of the surgical field (i.e., in a manner which is completely unrelated to the colonization of a surgical wound and its suture).
It should be noted that the final non-selective aerobic and facultative anaerobic bacteria counts in the placebo gel were significantly lower than in the chlorhexidine-chitosan gel. This was a surprising finding, given that it has previously been reported that the physical and chemical properties of this combination extend the effect of chlorhexidine in the mouth, when compared with the other gels75.
It was observed that, even though the placebo gel achieved a lower blood agar growth of bacteria when compared to the chlorhexidine-chitosan gel, this does not imply a direct relationship with wound healing given that, as other authors have also reported76, the chlorhexidine-chitosan gel managed to attain a significantly better degree of healing than the placebo gel. The effect of chitosan in favouring the healing process depends on individual host factors such as immunity, vascular parameters, and the molecules involved in bone regeneration such as RANK-RANKL-OPG77.
In future studies, it would be interesting to establish if any of the limited components present in the placebo gel formula could present an antimicrobial effect against the studied bacteria, given that it has been determined that it boasted certain advantages when compared with other gels (i.e., its recognized antimicrobial effect). The authors believe that this could be due to its strong adhesion to the surfaces on which it is applied, which as a consequence, prevents bacterial adhesion and the growth of biofilms.
In terms of the reduction in pain following the application of the different gels, the best rate was obtained from participants in the chlorhexidine gel group, with results of almost one point lower than the mean. However, this was not considered to be a statistically significant result. We can conclude that the mean post-surgical pain for this procedure was moderate; slightly over 4 out of 10 points. We did not observe any differences in the degree of facial swelling depending on the gel used.
The clear superiority of the chlorhexidine-chitosan gel in terms of the surgical healing state78 was associated with its chitosan content. This difference was observed both in the clinic and during statistical testing. The overall healing was significantly better in participants in the chlorhexidine-chitosan gel group than in those who used either the placebo gel or the hyaluronic acid gel, with p values of 0.027 and 0.011, respectively. No significant differences were observed when comparing it with the chlorhexidine gel alone, perhaps due to the sample size. Nonetheless, the mean surgical healing for chlorhexidine-chitosan was 0.83 points better than chlorhexidine alone.
No clear relationship between the microbiological parameters analyzed and the clinical aspects of pain and healing level was established.
The results which were obtained with the studied gels, in particular in terms of the healing quality, are considered to be useful when making recommendations to patients who have undergone a surgical procedure on their wisdom teeth and, by extension, to patients who have undergone general oral surgery.
Conclusions
The microbiological analyses revealed that none of the bioadhesive gels tested led to beneficial reductions in the bacterial/fungal populations. Likewise, none of the gels resulted in reduced post-surgical pain or facial swelling. The patients who were treated with chlorhexidine-chitosan gel healed better than those who were prescribed the placebo and the hyaluronic acid gels, and therefore this must be taken into consideration when prescribing medication following a surgical procedure to remove a lower third molar tooth.
References
Wes, J. T., Verweij, J. P., van der Ploeg, T., van Merkesteyn, J. P. R. & de Mol van Otterloo, J. J. Incision of the third molar in the Netherlands. Incision techniques for the removal of impacted third molars in the mandible. Ned Tijdschr Tandheelkd 124, 639–643 (2017).
Schwartz-Arad, D., Lipovsky, A., Pardo, M., Adut, O. & Dolev, E. Interpretations of complications following third molar extraction. Quintessence Int, 41-47 (2017).
Tortorici, S. et al. Prevalence and distribution of odontogenic cysts in Sicily: 1986-2005. J. Oral Sci. 50, 15–18 (2008).
Alves-Pereira, D., Pereira-Silva, D., Figueiredo, R., Gay-Escoda, C. & Valmaseda-Castellón, E. Clinician-related factors behind the decision to extract an asymptomatic lower third molar. A cross-sectional study based on Spanish and Portuguese dentists. Med Oral Patol Oral Cir Bucal 22, e60–e615 (2017).
Lopes, V., Mumenya, R., Feinmann, C. & Harris, M. Third molar surgery: an audit of the indications for surgery, post-operative complaints and patient satisfaction. Br. J. Oral Maxillofac. Surg. 33, 33–35 (1995).
Jo, Y. et al. Accelerated biodegradation of silk sutures through matrix metalloproteinase activation by incorporating 4-hexylresorcinol. Sci Rep 7, 42441 (2017).
Khoorjestan, S. M., Rouhi, G. & Toolabi, K. An investigation of the effects of suture patterns on mechanical strength of intestinal anastomosis: an experimental study. Biomed Tech (Berl) 62, 429–437 (2017).
González-Barnadas, A. et al. In Vitro Tensile Strength Study on Suturing Technique and Material. J Oral Implantol 43, 169–174 (2017).
Canales, J., Espinoza-Montes, C. & Alarcón-Palacios, M. Material de suturas en periodoncia e implantes. Rev.estomatol.Hered 23, 148–153 (2013).
Waite, P. D. & Cherala, S. Surgical outcomes for suture-less surgery in 366 impacted third molar patients. J. Oral Maxillofac. Surg. 64, 669–673 (2006).
Faria, R. L. et al. Antimicrobial activity of Calendula officinalis, Camellia sinensis and chlorhexidine against the adherence of microorganisms to sutures after extraction of unerupted third molars. J. Appl. Oral Sci. 19, 476–482 (2011).
Banche, G. et al. Microbial adherence on various intraoral suture materials in patients undergoing dental surgery. J. Oral Maxillofac. Surg. 65, 1503–1507 (2007).
Salinas, B. M., Riu, N. C., Aytés, L. B. & Escoda, C. G. Antibiotic susceptibility of the bacteria causing odontogenic infections. Med Oral Patol Oral Cir Bucal 11, 70 (2006).
Rodríguez Sánchez, F., Rodríguez Andrés, C. & Arteagoitia Calvo, I. Does Chlorhexidine Prevent Alveolar Osteitis After Third Molar Extractions? Systematic Review and Meta-Analysis. J. Oral Maxillofac. Surg. 75, 901–914 (2017).
Larsen, P. E. The effect of a chlorhexidine rinse on the incidence of alveolar osteitis following the surgical removal of impacted mandibular third molars. J. Oral Maxillofac. Surg. 49, 932–937 (1991).
Tomas, I. et al. Effect of a chlorhexidine mouthwash on the risk of postextraction bacteremia. Infect. Control Hosp. Epidemiol. 28, 577–582 (2007).
Isoshima, D. et al. Assessment of pathogenesis of infective endocarditis by plasma IgG antibody titer test against periodontal bacteria. Clin Case Rep 5, 1580–1586 (2017).
Lockhart, P. B. & Durack, D. T. Oral microflora as a cause of endocarditis and other distant site infections. Infect. Dis. Clin. North Am. 13, 83–50, vi (1999).
Balejo, R. D. P. et al. Effects of chlorhexidine preprocedural rinse on bacteremia in periodontal patients: a randomized clinical trial. J Appl Oral Sci 25, 586–595 (2017).
Groppo, F. C., Ramacciato, J. C., Simoes, R. P., Florio, F. M. & Sartoratto, A. Antimicrobial activity of garlic, tea tree oil, and chlorhexidine against oral microorganisms. Int. Dent. J. 52, 433–437 (2002).
Rindom Schiøtt, C. et al. The effect of chlorhexidine mouthrinses on the human oral flora. J. Periodont. Res. 5, 84–89 (1970).
Marrelli, M., Amantea, M. & Tatullo, M. A comparative, randomized, controlled study on clinical efficacy and dental staining reduction of a mouthwash containing Chlorhexidine 0.20% and Anti Discoloration System (ADS). Ann Stomatol (Roma) 6, 35–42 (2015).
Watts, A. & Addy, M. Tooth discolouration and staining: a review of the literature. Br. Dent. J. 190, 309–316 (2001).
Wang, M., Marks, L. E. & Frank, M. E. Taste coding after selective inhibition by chlorhexidine. Chem. Senses 34, 653–666 (2009).
Hepso, H. U., Bjornland, T. & Skoglund, L. A. Side-effects and patient acceptance of 0.2% versus 0.1% chlorhexidine used as post-operative prophylactic mouthwash. Int. J. Oral Maxillofac. Surg. 17, 17–20 (1988).
Van der Weijden, G. A., Ten Heggeler, J. M., Slot, D. E., Rosema, N. A. & Van der Velden, U. Parotid gland swelling following mouthrinse use. Int. J. Dent. Hyg. 8, 276–279 (2010).
Filoche, S. K., Soma, K. & Sissons, C. H. Antimicrobial effects of essential oils in combination with chlorhexidine digluconate. Oral Microbiol. Immunol. 20, 221–225 (2005).
Marya, C. M. et al. Efficacy of Chlorhexidine, Xylitol, and Chlorhexidine + Xylitol against Dental Plaque, Gingivitis, and Salivary Streptococcus mutans Load: A Randomised Controlled Trial. Oral Health Prev Dent 15, 529–536 (2017).
Flotra, L., Gjermo, P., Rolla, G. & Waerhaug, J. Side effects of chlorhexidine mouth washes. Scand. J. Dent. Res. 79, 119–125 (1971).
Motamedi, M. R. K. & Khazaei, S. Bioadhesive chlorhexidine gel for reduction of alveolar osteitis incidence: Systematic review and meta-analysis of randomized controlled trials. Dental Hypotheses 5, 35 (2014).
Senel, S. et al. Chitosan films and hydrogels of chlorhexidine gluconate for oral mucosal delivery. Int. J. Pharm. 193, 197–203 (2000).
Decker, E. M., von Ohle, C., Weiger, R., Wiech, I. & Brecx, M. A synergistic chlorhexidine/chitosan combination for improved antiplaque strategies. J. Periodontal. Res. 40, 373–377 (2005).
Frank, L. A. et al. The use of chitosan as cationic coating or gel vehicle for polymeric nanocapsules: Increasing penetration and adhesion of imiquimod in vaginal tissue. Eur J Pharm Biopharm 114, 202–212 (2017).
Ramírez, M. A., Cabrera, G., Gutiérrez, A. & Rodríguez, T. Metodología para la obtención de quitosana a bajas temperaturas a partir de quitina de langosta. Cultivos Tropicales 21, 81–84 (2000).
Kamjumphol, W., Chareonsudjai, P. & Chareonsudjai, S. Antibacterial activity of chitosan against Burkholderia pseudomallei. Microbiologyopen (2017).
D’Almeida, M. et al. Chitosan coating as an antibacterial surface for biomedical applications. PLoS ONE 12, e0189537 (2017).
Zheng, L. & Zhu, J. Study on antimicrobial activity of chitosan with different molecular weights. Carbohydr. Polym. 54, 527–530 (2003).
Leuba, J. L. & Stossel, P. in Chitin in nature and technology 215-222 (Springer, 1986).
Moraes, P. C. D. et al. Repair of Bone Defects with Chitosan-Collagen Biomembrane and Scaffold Containing Calcium Aluminate Cement. Braz Dent J 28, 287–295 (2017).
Zivanovic, S., Li, J., Davidson, P. M. & Kit, K. Physical, mechanical, and antibacterial properties of chitosan/PEO blend films. Biomacromolecules 8, 1505–1510 (2007).
Shamloo, A., Sarmadi, M., Aghababaie, Z. & Vossoughi, M. Accelerated full-thickness wound healing via sustained bFGF delivery based on a PVA/chitosan/gelatin hydrogel incorporating PCL microspheres. Int J Pharm (2017).
Berce, C. et al. Cutaneous wound healing using polymeric surgical dressings based on chitosan, sodium hyaluronate and resveratrol. A preclinical experimental study. Colloids Surf B Biointerfaces 163, 155–166 (2017).
Ueno, H., Mori, T. & Fujinaga, T. Topical formulations and wound healing applications of chitosan. Adv. Drug Deliv. Rev. 52, 105–115 (2001).
Raval, N., Khunt, D. & Misra, M. Microemulsion based delivery of Triamcinolone acetonide to posterior segment of eye using Chitosan and butter oil as permeation enhancer: An in vitro and in vivo investigation. J Microencapsul, 1-37 (2018).
Wang, T. et al. Chitosan nanoparticles loaded hydrogels promote skin wound healing through the modulation of reactive oxygen species. Artif Cells Nanomed Biotechnol, 1-12 (2017).
Ali, A. & Ahmed, S. A review on chitosan and its nanocomposites in drug delivery. Int. J. Biol. Macromol. 109, 273–286 (2017).
Leffler, C. C. & Muller, B. W. Influence of the acid type on the physical and drug liberation properties of chitosan-gelatin sponges. Int. J. Pharm. 194, 229–237 (2000).
Prabaharan, M. & Mano, J. F. Chitosan-based particles as controlled drug delivery systems. Drug Deliv. 12, 41–57 (2005).
Wang, X. et al. The exploration on blood coagulation of N-alkyl chitosan nanofiber membrane in vitro. Biomacromolecules (2018).
Rao, S. B. & Sharma, C. P. Use of chitosan as a biomaterial: studies on its safety and hemostatic potential. J. Biomed. Mater. Res. 34, 21–28 (1997).
Li, Z., Ramay, H. R., Hauch, K. D., Xiao, D. & Zhang, M. Chitosan-alginate hybrid scaffolds for bone tissue engineering. Biomaterials 26, 3919–3928 (2005).
Liang, X. et al. Rubbery Chitosan/Carrageenan Hydrogels Constructed through an Electroneutrality System and Their Potential Application as Cartilage Scaffolds. Biomacromolecules (2018).
Hsu, S. H. et al. Evaluation of chitosan-alginate-hyaluronate complexes modified by an RGD-containing protein as tissue-engineering scaffolds for cartilage regeneration. Artif. Organs 28, 693–703 (2004).
Shin, S. Y. et al. Biological evaluation of chitosan nanofiber membrane for guided bone regeneration. J. Periodontol. 76, 1778–1784 (2005).
Lin, D. M., Kalachandra, S., Valiyaparambil, J. & Offenbacher, S. A polymeric device for delivery of anti-microbial and anti-fungal drugs in the oral environment: effect of temperature and medium on the rate of drug release. Dent. Mater. 19, 589–596 (2003).
Bertolami, C. in Soft and hard tissue repair (Praeger Press, 1984).
Casale, M. et al. Systematic review: the efficacy of topical hyaluronic acid on oral ulcers. J. Biol. Regul. Homeost. Agents 31 (2017).
Casale, M. et al. Hyaluronic acid: Perspectives in dentistry. A systematic review. Int J Immunopathol Pharmacol 29, 572–582 (2016).
Ansari, S. et al. Human Periodontal Ligament- and Gingiva-derived Mesenchymal Stem Cells Promote Nerve Regeneration When Encapsulated in Alginate/Hyaluronic Acid 3D Scaffold. Adv Healthc Mater 6 (2017).
Lopez, M. A. et al. The use of hyaluronic acid as an adjuvant in the management of periodontitis. J. Biol. Regul. Homeost. Agents 31 (2017).
Pirnazar, P. et al. Bacteriostatic effects of hyaluronic acid. J. Periodontol. 70, 370–374 (1999).
Sakai, A. et al. Potential role of high molecular weight hyaluronan in the anti-Candida activity of human oral epithelial cells. Med. Mycol. 45, 73–79 (2007).
Lee, J. H., Jung, J. Y. & Bang, D. The efficacy of topical 0.2% hyaluronic acid gel on recurrent oral ulcers: comparison between recurrent aphthous ulcers and the oral ulcers of Behcet’s disease. J. Eur. Acad. Dermatol. Venereol. 22, 590–595 (2008).
Bansal, J., Kedige, S. D. & Anand, S. Hyaluronic acid: a promising mediator for periodontal regeneration. Indian J. Dent. Res. 21, 575–578 (2010).
Szolnoky, G., Szendi-Horváth, K., Seres, L., Boda, K. & Kemény, L. Manual lymph drainage efficiently reduces postoperative facial swelling and discomfort after removal of impacted third molars. Lymphology 40, 138–142 (2007).
Latt, M. M., Kiattavorncharoen, S., Boonsiriseth, K., Pairuchvej, V. & Wongsirichat, N. The efficacy of dexamethasone injection on postoperative pain in lower third molar surgery. Journal of Dental Anesthesia and Pain Medicine 16, 95 (2016).
Pell, G. J. & Gregory, B. T. Impacted mandibular third molars: classification and modified techniques for removal. Dent Digest 39, 330–338 (1933).
Winter, G. B. in Principles of exodontia as applied to the impacted mandibular third molar: a complete treatise on the operative technic with clinical diagnoses and radiographic interpretations (American medical book company, 1926).
Bloemen, M. C., Boekema, B. K., Vlig, M., van Zuijlen, P. P. & Middelkoop, E. Digital image analysis versus clinical assessment of wound epithelialization: a validation study. Burns 38, 501–505 (2012).
Falci, S. G. et al. Association between the presence of a partially erupted mandibular third molar and the existence of caries in the distal of the second molars. Int. J. Oral Maxillofac. Surg. 41, 1270–1274 (2012).
Raafat, D. & Sahl, H. Chitosan and its antimicrobial potential–a critical literature survey. Microbial biotechnology 2, 186–201 (2009).
Emilson, C. G. Potential efficacy of chlorhexidine against mutans streptococci and human dental caries. J. Dent. Res. 73, 682–691 (1994).
Chavez de Paz, L. E., Resin, A., Howard, K. A., Sutherland, D. S. & Wejse, P. L. Antimicrobial effect of chitosan nanoparticles on streptococcus mutans biofilms. Appl. Environ. Microbiol. 77, 3892–3895 (2011).
Kim, J. & Shin, D. Inhibitory effect on Streptococcus mutans and mechanical properties of the chitosan containing composite resin. Restorative dentistry & endodontics 38, 36–42 (2013).
Malik, S., Taneja, S., Chadha, R. & Kumari, M. Effect of Chitosan on sustained release of chlorhexidine–an in vitro study. Journal of Dental Specialities 4, 21–25 (2016).
Madrazo-Jimenez, M. et al. The effects of a topical gel containing chitosan, 0,2% chlorhexidine, allantoin and despanthenol on the wound healing process subsequent to impacted lower third molar extraction. Med. Oral Patol. Oral Cir. Bucal 21, e69–e702 (2016).
Perez-Sayans, M., Somoza-Martin, J. M., Barros-Angueira, F., Rey, J. M. & Garcia-Garcia, A. RANK/RANKL/OPG role in distraction osteogenesis. Oral Surg. Oral Med. Oral Pathol. Oral Radiol. Endod. 109, 679–686 (2010).
Dai, T., Tanaka, M., Huang, Y. & Hamblin, M. R. Chitosan preparations for wounds and burns: antimicrobial and wound-healing effects. Expert review of anti-infective therapy 9, 857–879 (2011).
Acknowledgements
The work was supported by the Oral Medicine, Oral surgery and Implantology Unit. School of Medicine and Dentistry, University of Santiago de Compostela, Santiago de Compostela, Spain.
Author information
Authors and Affiliations
Contributions
S.R. and A.B. contributed to the study design. X.M. and M.P. contributed to the statistical analysis. R.S. and A.P. contributed to the laboratory analysis. S.R. performed the clinical phase. S.R., M.P., A.G. and P.G. contributed to the writing of the article.
Corresponding author
Ethics declarations
Competing interests
The authors declare no competing interests.
Additional information
Publisher’s note Springer Nature remains neutral with regard to jurisdictional claims in published maps and institutional affiliations.
Rights and permissions
Open Access This article is licensed under a Creative Commons Attribution 4.0 International License, which permits use, sharing, adaptation, distribution and reproduction in any medium or format, as long as you give appropriate credit to the original author(s) and the source, provide a link to the Creative Commons license, and indicate if changes were made. The images or other third party material in this article are included in the article’s Creative Commons license, unless indicated otherwise in a credit line to the material. If material is not included in the article’s Creative Commons license and your intended use is not permitted by statutory regulation or exceeds the permitted use, you will need to obtain permission directly from the copyright holder. To view a copy of this license, visit http://creativecommons.org/licenses/by/4.0/.
About this article
Cite this article
Rodríguez Zorrilla, S., Blanco Carrión, A., García García, A. et al. Effect of antiseptic gels in the microbiologic colonization of the suture threads after oral surgery. Sci Rep 10, 8360 (2020). https://doi.org/10.1038/s41598-020-65007-y
Received:
Accepted:
Published:
Version of record:
DOI: https://doi.org/10.1038/s41598-020-65007-y
This article is cited by
-
Selective outcome reporting concerning antibiotics and third molar surgery
Clinical Oral Investigations (2025)
-
Evaluation of the effects of Andiz extract on the experimentally wound in rats by microbiological and gene expression methods
Molecular Biology Reports (2025)